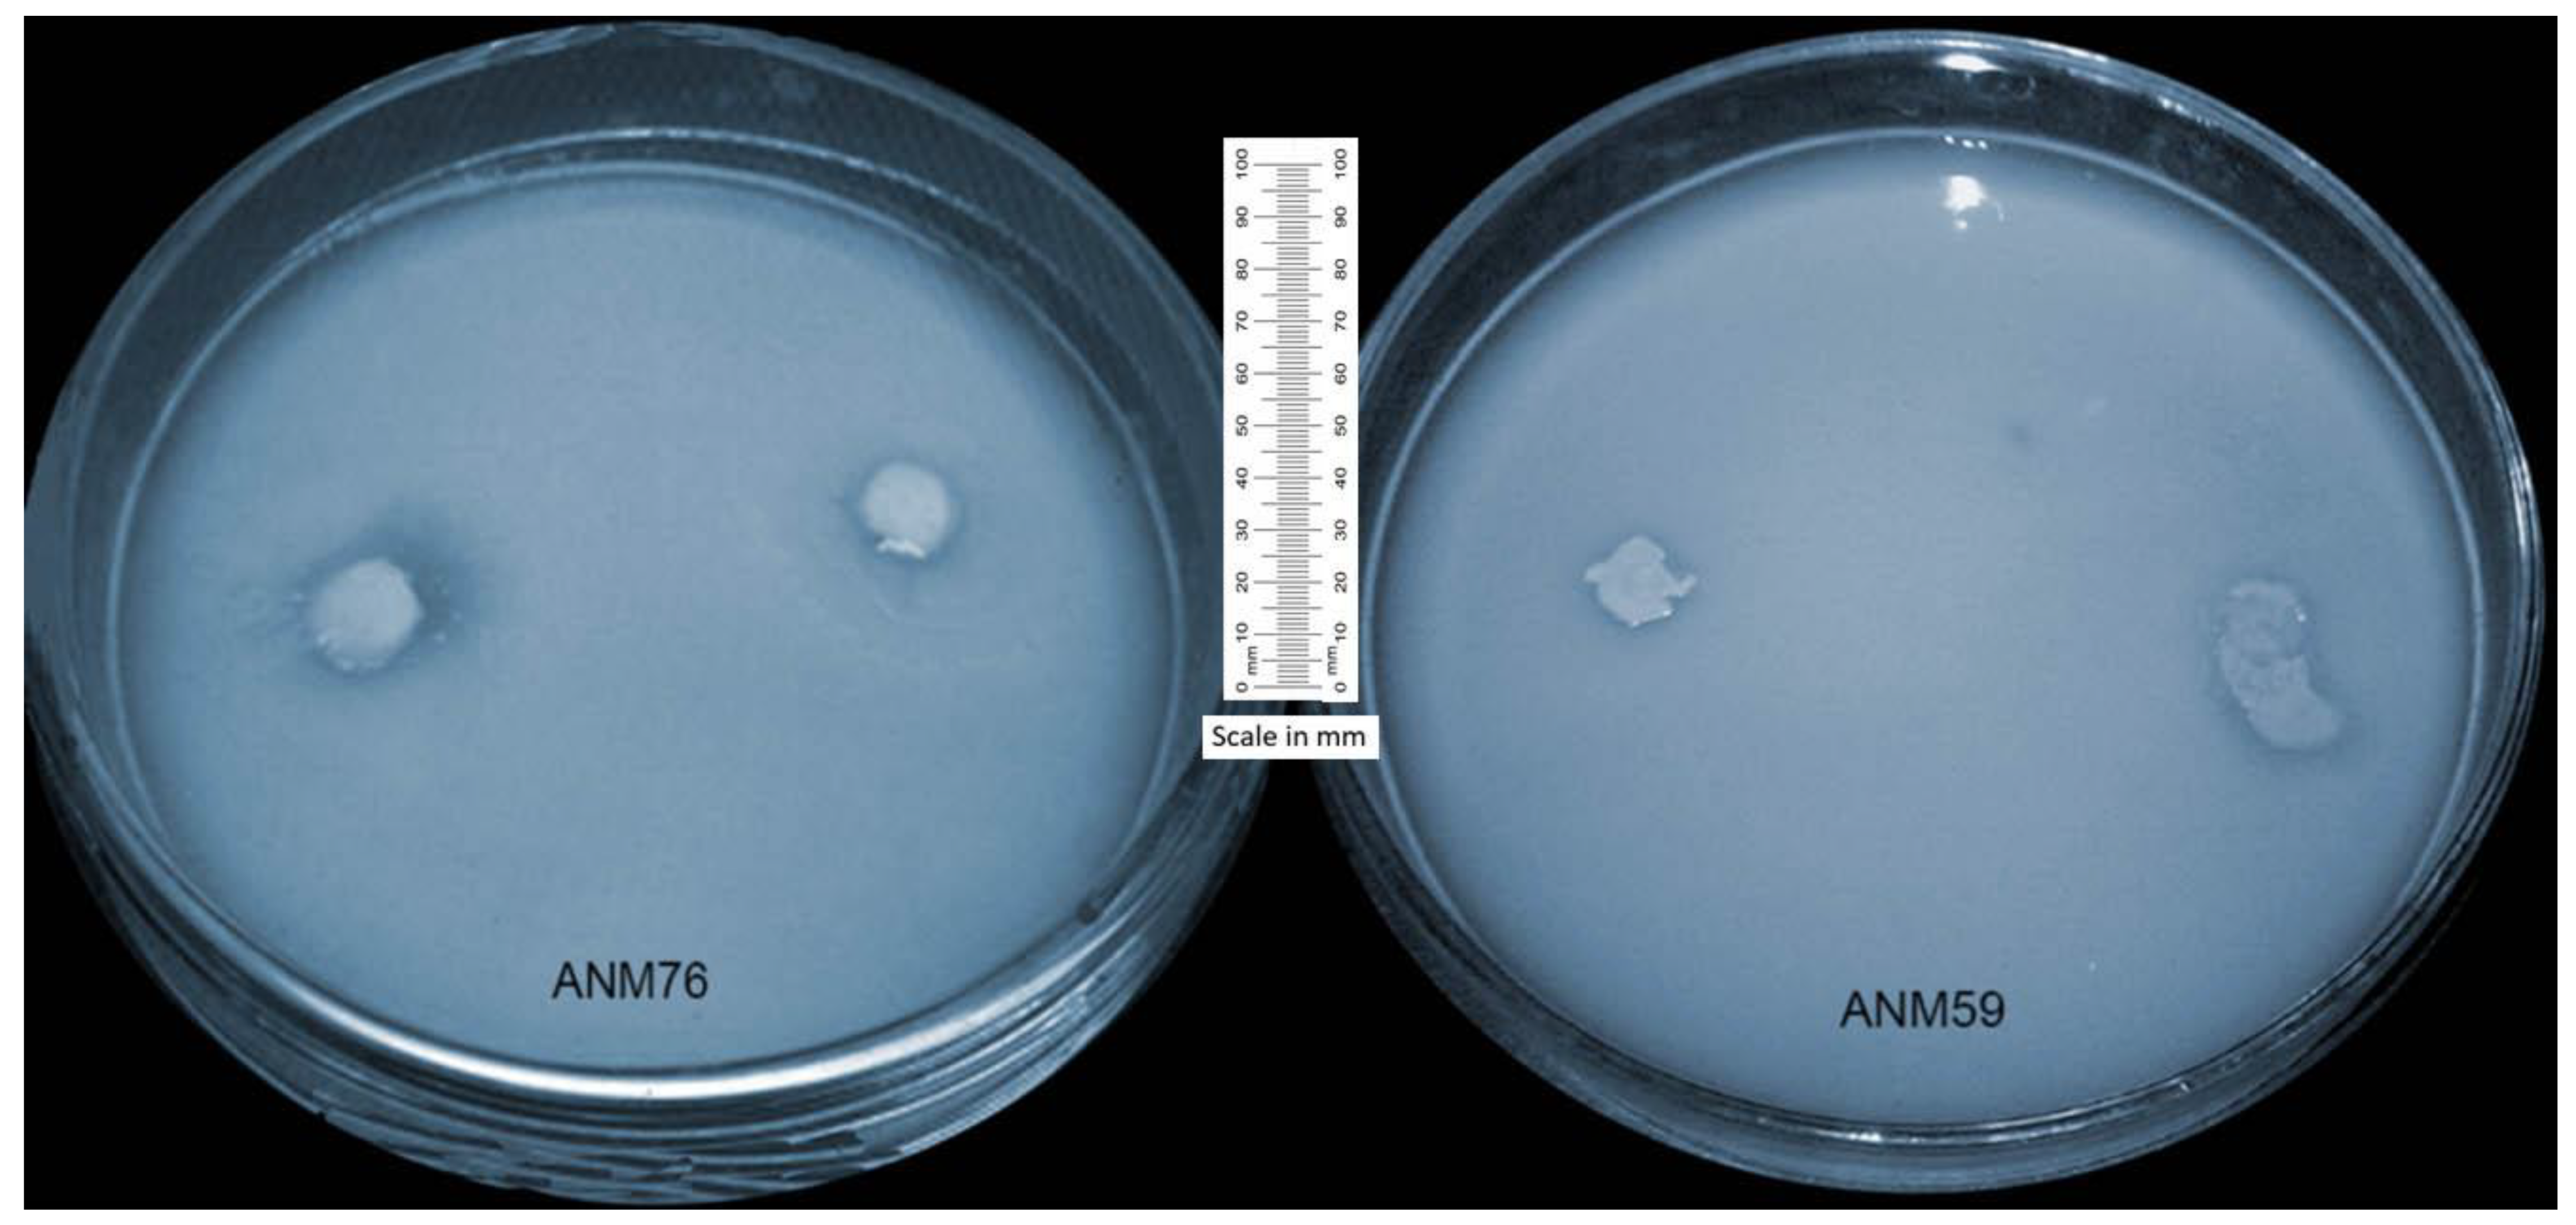
Agronomy 09 00621 g001

Appraising Endophyte–Plant Symbiosis for Improved Growth, Nodulation, Nitrogen Fixation and Abiotic Stress Tolerance: An Experimental Investigation with Chickpea (Cicer arietinum L.)
Abstract
1. Introduction
2. Materials and Methods
2.1. Isolation of Endophytic Strains
2.2. Authentication of Endophytic Nature of Strains
2.3. In Vitro Screening of Endophytes for their PGP Characteristics
2.4. In Vitro Screening for Stress Tolerance
2.5. Screening of Endophytes for Growth Promotion of Chickpea (Jar Trial)
2.6. Identification of Selected Endophytic Strains
2.7. Statistical Assessment
3. Results
3.1. Morphological Characteristics of Endophytes
3.2. Endophytic Strains Possess PGP Characteristics
3.3. Endophytic Strains were Salinity, pH and Heavy Metals Stress Tolerant
3.4. Endophytic Strains Promoted the Growth and Nodulation in Chickpea (Jar Trial)
3.5. Identification of Selected Strains through 16S rRNA
4. Discussion
5. Conclusions
Supplementary Materials
Author Contributions
Funding
Acknowledgments
Conflicts of Interest
References
- Jukanti, A.K.; Gaur, P.M.; Gowda, C.L.L.; Chibbar, R.N. Nutritional quality and health benefits of chickpea (Cicer arietinumL.): A review. Br. J. Nutr. 2012, 108, S11–S26. [Google Scholar] [CrossRef] [PubMed]
- Sulieman, S.; Tran, L.S.P. Asparagine: An Amide of Particular Distinction in the Regulation of Symbiotic Nitrogen Fixation of Legumes. Crit. Rev. Biotechnol. 2013, 33, 309–327. [Google Scholar] [CrossRef] [PubMed]
- Gouda, S.; Kerry, R.G.; Das, G.; Paramithiotis, S.; Shin, H.-S.; Patra, J.K. Revitalization of plant growth promoting rhizobacteria for sustainable development in agriculture. Microbiol. Res. 2018, 206, 131–140. [Google Scholar] [CrossRef]
- Martínez-Hidalgo, P.; Hirsch, A.M. The Nodule Microbiome: N2-Fixing Rhizobia Do Not Live Alone. Phytobiomes J. 2017, 1, 70–82. [Google Scholar] [CrossRef]
- Lu, J.; Yang, F.; Wang, S.; Ma, H.; Liang, J.; Chen, Y. Co-existence of Rhizobia and Diverse Non-rhizobial Bacteria in the Rhizosphere and Nodules of Dalbergia odorifera Seedlings Inoculated with Bradyrhizobium elkanii, Rhizobium multihospitium–Like and Burkholderia pyrrocinia–Like Strains. Front. Microbiol. 2017, 8, 2255. [Google Scholar] [CrossRef] [PubMed]
- Peix, A.; Ramírez-Bahena, M.H.; Velázquez, E.; Bedmar, E.J. Bacterial Associations with Legumes. CRC Crit. Rev. Plant Sci. 2015, 34, 17–42. [Google Scholar] [CrossRef]
- Santoyo, G.; Moreno-Hagelsieb, G.; Orozco-Mosqueda, M.D.C.; Glick, B.R. Plant growth-promoting bacterial endophytes. Microbiol. Res. 2016, 183, 92–99. [Google Scholar] [CrossRef]
- Haidar, B.; Ferdous, M.; Fatema, B.; Ferdous, A.S.; Islam, M.R.; Khan, H. Population diversity of bacterial endophytes from jute (Corchorus olitorius) and evaluation of their potential role as bioinoculants. Microbiol. Res. 2018, 208, 43–53. [Google Scholar] [CrossRef]
- Berendsen, R.L.; Pieterse, C.M.; Bakker, P.A. The rhizosphere microbiome and plant health. Trends Plant Sci. 2012, 17, 478–486. [Google Scholar] [CrossRef]
- Ali, M.A.; Naveed, M.; Mustafa, A.; Abbas, A. The Good, the Bad, and the Ugly of Rhizosphere Microbiome. In Probiotics and Plant Health; Springer Science and Business Media LLC: Berlin, Germany, 2017; pp. 253–290. [Google Scholar]
- Timmusk, S.; Paalme, V.; Pavlícek, T.; Bergquist, J.; Vangala, A.; Danilas, T.; Nevo, E. Bacterial Distribution in the Rhizosphere of Wild Barley under Contrasting Microclimates. PLoS ONE 2011, 6, e17968. [Google Scholar] [CrossRef]
- Huang, J. Ultrastructure of Bacterial Penetration in Plants. Annu. Rev. Phytopathol. 1986, 24, 141–157. [Google Scholar] [CrossRef]
- Hallmann, J.; Quadt-Hallmann, A.; Mahaffee, W.F.; Kloepper, J.W. Bacterial endophytes in agricultural crops. Can. J. Microbiol. 1997, 43, 895–914. [Google Scholar] [CrossRef]
- Ryan, R.P.; Germaine, K.; Franks, A.; Ryan, D.J.; Dowling, D.N. Bacterial endophytes: recent developments and applications. FEMS Microbiol. Lett. 2008, 278, 1–9. [Google Scholar] [CrossRef]
- Sun, L.; Qiu, F.; Zhang, X.; Dai, X.; Dong, X.; Song, W. Endophytic Bacterial Diversity in Rice (Oryza sativa L.) Roots Estimated by 16S RDNA Sequence Analysis. Microb. Ecol. 2008, 55, 415–424. [Google Scholar] [PubMed]
- Pedrosa, F.O.; Monteiro, R.A.; Wassem, R.; Cruz, L.M.; Ayub, R.A.; Colauto, N.B.; Fernandez, M.A.; Fungaro, M.H.P.; Grisard, E.C.; Hungria, M.; et al. Genome of Herbaspirillum seropedicae Strain SmR1, a Specialized Diazotrophic Endophyte of Tropical Grasses. PLoS Genet. 2011, 7, e1002064. [Google Scholar] [CrossRef] [PubMed]
- Shi, Y.; Yang, H.; Zhang, T.; Sun, J.; Lou, K. Illumina-based analysis of endophytic bacterial diversity and space-time dynamics in sugar beet on the north slope of Tianshan mountain. Appl. Microbiol. Biotechnol. 2014, 98, 6375–6385. [Google Scholar] [CrossRef] [PubMed]
- Abbamondi, G.R.; Tommonaro, G.; Weyens, N.; Thijs, S.; Sillen, W.; Gkorezis, P.; Iodice, C.; Rangel, W.D.M.; Nicolaus, B.; Vangronsveld, J. Plant growth-promoting effects of rhizospheric and endophytic bacteria associated with different tomato cultivars and new tomato hybrids. Chem. Boil. Technol. Agric. 2016, 3, 11. [Google Scholar] [CrossRef]
- Kumar, A.; Singh, R.; Yadav, A.; Giri, D.D.; Singh, P.K.; Pandey, K.D. Isolation and characterization of bacterial endophytes of Curcuma longa L. 3 Biotech 2016, 6, 60. [Google Scholar] [CrossRef]
- Muthukumar, A.; Udhayakumar, R.; Naveenkumar, R. Role of Bacterial Endophytes in Plant Disease Control. In Endophytes: Crop Productivity and Protection; Springer Science and Business Media LLC: Berlin, Germany, 2017; Volume 16, pp. 133–161. [Google Scholar]
- Liotti, R.G.; Figueiredo, M.I.D.S.; Da Silva, G.F.; De Mendonça, E.A.F.; Soares, M.A. Diversity of cultivable bacterial endophytes in Paullinia cupana and their potential for plant growth promotion and phytopathogen control. Microbiol. Res. 2018, 207, 8–18. [Google Scholar] [CrossRef]
- Eida, A.A.; Alzubaidy, H.S.; de Zélicourt, A.; Synek, L.; Alsharif, W.; Lafi, F.F.; Hirt, H.; Saad, M.M. Phylogenetically Diverse Endophytic Bacteria from Desert Plants Induce Transcriptional Changes of Tissue-Specific Ion Transporters and Salinity Stress in Arabidopsis. Plant Sci. 2019, 280, 228–240. [Google Scholar] [CrossRef]
- Glick, B.R.; Todorovic, B.; Czarny, J.; Cheng, Z.; Duan, J.; McConkey, B. Promotion of Plant Growth by Bacterial ACC Deaminase. Crit. Rev. Plant Sci. 2007, 26, 227–242. [Google Scholar] [CrossRef]
- Glick, B.R.; Cheng, Z.; Czarny, J.; Duan, J. Promotion of plant growth by ACC deaminase-producing soil bacteria. Eur. J. Plant Pathol. 2007, 119, 329–339. [Google Scholar] [CrossRef]
- Prasanna, R.; Ramakrishnan, B.; Simranjit, K.; Ranjan, K.; Kanchan, A.; Hossain, F.; Nain, L. Cyanobacterial and rhizobial inoculation modulates the plant physiological attributes and nodule microbial communities of chickpea. Arch. Microbiol. 2017, 199, 1311–1323. [Google Scholar] [CrossRef] [PubMed]
- Hardoim, P.R.; Van Overbeek, L.S.; Van Elsas, J.D. Properties of bacterial endophytes and their proposed role in plant growth. Trends Microbiol. 2008, 16, 463–471. [Google Scholar] [CrossRef]
- Rashid, S.; Charles, T.C.; Glick, B.R. Isolation and characterization of new plant growth-promoting bacterial endophytes. Appl. Soil Ecol. 2012, 61, 217–224. [Google Scholar] [CrossRef]
- Datta, C.; Basu, P. Indole acetic acid production by a Rhizobium species from root nodules of a leguminous shrub, Cajanus cajan. Microbiol. Res. 2000, 155, 123–127. [Google Scholar] [CrossRef]
- Duca, D.; Lorv, J.; Patten, C.L.; Rose, D.; Glick, B.R. Indole-3-acetic acid in plant–microbe interactions. Antonie van Leeuwenhoek 2014, 106, 85–125. [Google Scholar] [CrossRef]
- Reetha, S.; Bhuvaneswari, G.; Thamizhiniyan, P.; Mycin, T.R. Isolation of Indole Acetic Acid (IAA) Producing Rhizobacteria of Pseudomonas fluorescens and Bacillus subtilis and Enhance Growth of Onion (Allim cepa L.). Int. J. Curr. Microbiol. Appl. Sci. 2014, 3, 568–574. [Google Scholar]
- Dhungana, S.A.; Itoh, K. Effects of Co-Inoculation of Indole-3-Acetic Acid-Producing and -Degrading Bacterial Endophytes on Plant Growth. Horticulturae 2019, 5, 17. [Google Scholar] [CrossRef]
- Chernin, L.; Chet, I. Microbial Enzymes in the Biocontrol of Plant Pathogens and Pests. In Water Policy and Planning in a Variable and Changing Climate; Informa UK Limited: Colchester, UK, 2002; Volume 84, pp. 179–234. [Google Scholar]
- Ma, Y.; Rajkumar, M.; Zhang, C.; Freitas, H. Beneficial role of bacterial endophytes in heavy metal phytoremediation. J. Environ. Manag. 2016, 174, 14–25. [Google Scholar] [CrossRef]
- Kannojia, P.; Choudhary, K.K.; Srivastava, A.K.; Singh, A.K. PGPR Bioelicitors: Induced Systemic Resistance (ISR) and Proteomic Perspective on Biocontrol. In PGPR Amelioration in Sustainable Agriculture: Food Security and Environmental Management; Singh, A.K., Kumar, A., Singh, P.K., Eds.; Woodhead Publishing: Cambridge, UK, 2019; pp. 67–84. [Google Scholar]
- Al-Adham, I.; Haddadin, R.; Collier, P. Types of Microbicidal and Microbistatic Agents. In Russell, Hugo & Ayliffe’s: Principles and Practice of Disinfection, Preservation and Sterilization; Fraise, A.P., Maillard, J.Y., Sattar, S., Eds.; Wiley-Blackwell: Oxford, UK, 2012; pp. 5–70. [Google Scholar]
- Vincent, J.M. A Manual for the Practical Study of the Root-Nodule Bacteria; Blackwell Scientific Publications: Oxford and Edinburgh, UK, 1970; pp. 153–159. [Google Scholar]
- Pikovskaya, R.I. Mobilization of Phosphorus in Soil in Connection with Vital Activity of Some Microbial Species. Mikrobiologiya 1948, 17, 362–370. [Google Scholar]
- Vazquez, P.; Holguín, G.; Puente, M.E.; Lopez-Cortes, A.; Bashan, Y. Phosphate-solubilizing microorganisms associated with the rhizosphere of mangroves in a semiarid coastal lagoon. Boil. Fertil. Soils 2000, 30, 460–468. [Google Scholar] [CrossRef]
- Premono, M.; Moawad, A.; Vlek, P. Effect of Phosphate-Solubilizing Pseudomonas putida on the Growth of Maize and Its Survival in the Rhizosphere. Indones. J. Crop Sci. 1996, 11, 13–23. [Google Scholar]
- Singh, S.M.; Yadav, L.S.; Singh, S.K.; Singh, P.; Singh, P.N.; Ravindra, R. Phosphate solubilizing ability of two Arctic Aspergillus niger strains. Polar Res. 2011, 30, 7283. [Google Scholar]
- Fasim, F.; Ahmed, N.; Parsons, R.; Gadd, G.M. Solubilization of zinc salts by a bacterium isolated from the air environment of a tannery. FEMS Microbiol. Lett. 2002, 213, 1–6. [Google Scholar] [CrossRef] [PubMed]
- Mumtaz, M.Z.; Ahmad, M.; Jamil, M.; Hussain, T. Zinc Solubilizing Bacillus Spp. Potential Candidates for Biofortification in Maize. Microbiol. Res. 2017, 202, 51–60. [Google Scholar]
- Cappuccino, J.; Welsh, C. Microbiology: A Laboratory Manual, 11th ed.; Pearson: New York, NY, USA, 2017; pp. 163–232. [Google Scholar]
- Ali, B.; Hasnain, S. Efficacy of Bacterial Auxin on in Vitro Growth of Brassica oleracea L. World J. Microbiol. Biotechnol. 2007, 23, 779–784. [Google Scholar] [CrossRef]
- Tang, W.Y.; Borner, J. Enzymes Involved in Synthesis and Breakdown of Indoleacetic Acid. Mod. Methods Plant Anal. 1979, 7, 238–241. [Google Scholar]
- Chernin, L.S.; Winson, M.K.; Thompson, J.M.; Haran, S.; Bycroft, B.W.; Chet, I.; Williams, P.; Stewart, G.S.A.B. Chitinolytic Activity in Chromobacterium violaceum: Substrate Analysis and Regulation by Quorum Sensing. J. Bacteriol. 1998, 180, 4435–4441. [Google Scholar]
- De Oliveira, A.N.; De Oliveira, L.A.; Andrade, J.S.; Junior, A.F.C. Rhizobia amylase production using various starchy substances as carbon substrates. Braz. J. Microbiol. 2007, 38, 208–216. [Google Scholar] [CrossRef]
- Mendis, H.C.; Thomas, V.P.; Schwientek, P.; Salamzade, R.; Chien, J.-T.; Waidyarathne, P.; Kloepper, J.; De La Fuente, L. Strain-specific quantification of root colonization by plant growth promoting rhizobacteria Bacillus firmus I-1582 and Bacillus amyloliquefaciens QST713 in non-sterile soil and field conditions. PLoS ONE 2018, 13, e0193119. [Google Scholar] [CrossRef] [PubMed]
- Carrasco, J.A.; Armario, P.; Pajuelo, E.; Burgos, A.; Caviedes, M.A.; López, R.; Chamber, M.A.; Palomares, A.J.; López-Núñez, R. Isolation and characterisation of symbiotically effective Rhizobium resistant to arsenic and heavy metals after the toxic spill at the Aznalcóllar pyrite mine. Soil Boil. Biochem. 2005, 37, 1131–1140. [Google Scholar] [CrossRef]
- Macrogen, Seoul, Korea. Available online: https://dna.macrogen.com/eng/ (accessed on 23 March 2019).
- Kumar, S.; Stecher, G.; Tamura, K. MEGA7: Molecular Evolutionary Genetics Analysis version 7.0 for bigger datasets. Mol. Boil. Evol. 2016, 33, 1870–1874. [Google Scholar] [CrossRef] [PubMed]
- Tamura, K.; Nei, M.; Kumar, S. Prospects for inferring very large phylogenies by using the neighbor-joining method. Proc. Natl. Acad. Sci. USA 2004, 101, 11030–11035. [Google Scholar] [CrossRef]
- Gomez, K.A.; Gomez, A.A. Statistical Procedures for Agricultural Research, 2nd ed.; John Wiley & Sons: New York, NY, USA, 1984; pp. 187–240. [Google Scholar]
- Dudeja, S.S.; Giri, R.; Saini, R.; Suneja-Madan, P.; Kothe, E. Interaction of Endophytic Microbes with Legumes. J. Basic Microbiol. 2012, 52, 248–260. [Google Scholar] [CrossRef] [PubMed]
- Weir, B.S. The Current Taxonomy of Rhizobia. Available online: https://www.rhizobia.co.nz/taxonomy/rhizobia (accessed on 3 May 2019).
- Saini, R.; Dudeja, S.S.; Giri, R.; Kumar, V. Isolation, characterization, and evaluation of bacterial root and nodule endophytes from chickpea cultivated in Northern India. J. Basic Microbiol. 2013, 55, 74–81. [Google Scholar] [CrossRef] [PubMed]
- Idris, E.E.; Iglesias, D.J.; Talón, M.; Borriss, R. Tryptophan-Dependent Production of Indole-3-Acetic Acid (IAA) Affects Level of Plant Growth Promotion by Bacillus amyloliquefaciens FZB42. Mol. Plant.-Microbe Interactions 2007, 20, 619–626. [Google Scholar] [CrossRef]
- Khan, A.L.; Halo, B.A.; Elyassi, A.; Ali, S.; Al-Hosni, K.; Hussain, J.; Al-Harrasi, A.; Lee, I.-J. Indole acetic acid and ACC deaminase from endophytic bacteria improves the growth of Solanum lycopersicum. Electron. J. Biotechnol. 2016, 21, 58–64. [Google Scholar] [CrossRef]
- Spaepen, S.; Vanderleyden, J.; Remans, R. Indole-3-acetic acid in microbial and microorganism-plant signaling. FEMS Microbiol. Rev. 2007, 31, 425–448. [Google Scholar] [CrossRef]
- Patten, C.L.; Glick, B.R. Role of Pseudomonas putida Indoleacetic Acid in Development of the Host Plant Root System. Appl. Environ. Microbiol. 2002, 68, 3795–3801. [Google Scholar] [CrossRef]
- James, E.K.; Gyaneshwar, P.; Mathan, N.; Barraquio, W.L.; Reddy, P.M.; Iannetta, P.P.M.; Olivares, F.L.; Ladha, J.K. Infection and Colonization of Rice Seedlings by the Plant Growth-Promoting Bacterium Herbaspirillum seropedicae Z67. Mol. Plant.-Microbe Interactions 2002, 15, 894–906. [Google Scholar] [CrossRef] [PubMed]
- Chi, F.; Shen, S.-H.; Cheng, H.-P.; Jing, Y.-X.; Yanni, Y.G.; Dazzo, F.B. Ascending Migration of Endophytic Rhizobia, from Roots to Leaves, inside Rice Plants and Assessment of Benefits to Rice Growth Physiology. Appl. Environ. Microbiol. 2005, 71, 7271–7278. [Google Scholar] [CrossRef] [PubMed]
- Vessey, J.K. Plant growth promoting rhizobacteria as biofertilizers. Plant Soil 2003, 255, 571–586. [Google Scholar] [CrossRef]
- Khan, M.S.; Zaidi, A.; Ahmad, E. Mechanism of Phosphate Solubilization and Physiological Functions of Phosphate-Solubilizing Microorganisms. In Phosphate Solubilizing Microorganisms; Springer Science and Business Media LLC: Berlin, Germany, 2014; pp. 31–62. [Google Scholar]
- Kpomblekou-A, K.; Tabatabai, M.A. Effect of Organic Acids on release of Phosphorus from Phosphate Rocks. Soil Sci. 1994, 158, 442–453. [Google Scholar] [CrossRef]
- Seshachala, U.; Tallapragada, P. Phosphate Solubilizers from the Rhizospher of Piper nigrum L. in Karnataka, India. Chil. J. Agric. Res. 2012, 72, 397–403. [Google Scholar] [CrossRef]
- Chernin, L.; Ismailov, Z.; Haran, S.; Chet, I. Chitinolytic Enterobacter agglomerans Antagonistic to Fungal Plant Pathogens. Appl. Environ. Microbiol. 1995, 61, 1720–1726. [Google Scholar]
- Husson, E.; Hadad, C.; Huet, G.; Laclef, S.; Lesur, D.; Lambertyn, V.; Jamali, A.; Gottis, S.; Sarazin, C.; Van Nhien, A.N. The effect of room temperature ionic liquids on the selective biocatalytic hydrolysis of chitin via sequential or simultaneous strategies. Green Chem. 2017, 19, 4122–4131. [Google Scholar] [CrossRef]
- Friedrich, N.; Hagedorn, M.; Soldati-Favre, D.; Soldati, T. Prison Break: Pathogens’ Strategies To Egress from Host Cells. Microbiol. Mol. Boil. Rev. 2012, 76, 707–720. [Google Scholar] [CrossRef] [PubMed]
- Koby, S.; Schickler, H.; Ilan, C.; Oppenheim, A.B. The chitinase encoding Tn7-based chiA gene endows Pseudomonas fluorescens with the capacity to control plant pathogens in soil. Gene 1994, 147, 81–83. [Google Scholar] [CrossRef]
- Kowsari, M.; Zamani, M.R.; Motallebi, M. Overexpression of Chimeric Chitinase42 Enhanced Antifungal Activity of Trichoderma harzianum against Fusarium graminearum. Mycol. Iran. 2016, 3, 15–23. [Google Scholar]
- Yedidia, I.; Benhamou, N.; Chet, I. Induction of Defense Responses in Cucumber Plants (Cucumis sativus L.) by the Biocontrol Agent Trichoderma harzianum. Appl. Environ. Microbiol. 1999, 65, 1061–1070. [Google Scholar] [PubMed]
- Palaniappan, P.; Chauhan, P.S.; Saravanan, V.S.; Anandham, R.; Sa, T. Isolation and characterization of plant growth promoting endophytic bacterial isolates from root nodule of Lespedeza sp. Boil. Fertil. Soils 2010, 46, 807–816. [Google Scholar] [CrossRef]
- Hung, P.Q.; Kumar, S.M.; Govindsamy, V.; Annapurna, K. Isolation and characterization of endophytic bacteria from wild and cultivated soybean varieties. Boil. Fertil. Soils 2007, 44, 155–162. [Google Scholar] [CrossRef]
- Dsouza, M.; Taylor, M.W.; Ryan, J.; MacKenzie, A.; Lagutin, K.; Anderson, R.F.; Turner, S.J.; Aislabie, J. Paenibacillus darwinianus Sp. Nov., Isolated from Gamma-Irradiated Antarctic Soil. Int. J. Syst. Evol. Microbiol. 2014, 64, 1406–1411. [Google Scholar] [CrossRef] [PubMed]
- Kittiwongwattana, C.; Thawai, C. Paenibacillus lemnae Sp. Nov., an Endophytic Bacterium of Duckweed (Lemna aequinoctialis). Int. J. Syst. Evol. Microbiol. 2015, 65, 107–112. [Google Scholar] [CrossRef] [PubMed]
- Valverde, A.; Fterich, A.; Mahdhi, M.; Ramirez-Bahena, M.-H.; Caviedes, M.A.; Mars, M.; Velazquez, E.; Rodriguez-Llorente, I.D. Paenibacillus prosopidis Sp. Nov., Isolated from the Nodules of Prosopis farcta. Int. J. Syst. Evol. Microbiol. 2010, 60, 2182–2186. [Google Scholar] [CrossRef] [PubMed]
- Wang, L.; Baek, S.-H.; Cui, Y.; Lee, H.-G.; Lee, S.-T. Paenibacillus sediminis Sp. Nov., a Xylanolytic Bacterium Isolated from a Tidal Flat. Int. J. Syst. Evol. Microbiol. 2012, 62, 1284–1288. [Google Scholar] [CrossRef] [PubMed]
- Beveridge, T.J. Mechanism of gram variability in select bacteria. J. Bacteriol. 1990, 172, 1609–1620. [Google Scholar] [CrossRef]
- Park, J.-W.; Balaraju, K.; Kim, J.-W.; Lee, S.-W.; Park, K. Systemic resistance and growth promotion of chili pepper induced by an antibiotic producing Bacillus vallismortis strain BS07. Boil. Control. 2013, 65, 246–257. [Google Scholar] [CrossRef]
- Egamberdieva, D.; Wirth, S.J.; Shurigin, V.V.; Hashem, A.; Abd_Allah, E.F. Endophytic Bacteria Improve Plant Growth, Symbiotic Performance of Chickpea (Cicer arietinum L.) and Induce Suppression of Root Rot Caused by Fusarium solani under Salt Stress. Front. Microbiol. 2017, 8, 8. [Google Scholar] [CrossRef]
- Parray, J.A.; Kamili, A.N.; Reshi, Z.A.; Qadri, R.A.; Jan, S. Interaction of Rhizobacterial Strains for Growth Improvement of Crocus Sativus, L. under Tissue Culture Conditions. Plant Cell. Tissue Organ Cult. 2015, 121, 325–334. [Google Scholar] [CrossRef]
- Beneduzi, A.; Costa, P.B.; Parma, M.; Melo, I.S.; Bodanese-Zanettini, M.H.; Passaglia, L.M.P. Paenibacillus riograndensis Sp. Nov., a Nitrogen-Fixing Species Isolated from the Rhizosphere of Triticum aestivum. Int. J. Syst. Evol. Microbiol. 2010, 60, 128–133. [Google Scholar] [PubMed]
- Xie, J.-B.; Du, Z.; Bai, L.; Tian, C.; Zhang, Y.; Xie, J.-Y.; Wang, T.; Liu, X.; Chen, X.; Cheng, Q.; et al. Comparative Genomic Analysis of N2-Fixing and Non-N2-Fixing Paenibacillus Spp.: Organization, Evolution and Expression of the Nitrogen Fixation Genes. PLoS Genet. 2014, 10, e1004231. [Google Scholar]
- da Silva, V.N.; da Silva, L.E.S.F.; Martinez, C.R.; Seldin, L.; Burity, H.A.; Figueiredo, M.V.B. Strains of Paenibacillus Promoters of the Specific Nodulation in the Symbiosis Bradyrhizobium caupi. Acta Sci. Agron. 2007, 29, 331–338. [Google Scholar] [CrossRef][Green Version]
- Latif, S.; Khan, S.U.; Naveed, M.; Mustafa, G.; Bashir, T.; Mumtaz, A.S. The diversity of Rhizobia, Sinorhizobia and novel non-Rhizobial Paenibacillus nodulating wild herbaceous legumes. Arch. Microbiol. 2013, 195, 647–653. [Google Scholar] [CrossRef]

| Strains | Production of IAA (mg L−1) a | Phosphate Solubilization b | Colloidal Chitin Solubilization c | Root Colonization d | |||||
|---|---|---|---|---|---|---|---|---|---|
| Without L-Tryptophan | With L-Tryptophan | P Halo Zone (mm) | PSE (%) | PSI | Colloidal Halo Zone (mm) | CSE (%) | CSI | ||
| ANM9 | 4.78 ± 0.003 | 6.79 ± 0.005 | ND e | ND | ND | 9.67 ± 0.666 | 145± 3.316 | 2.45 ± 0.019 | NS f |
| ANM12 | 3.67 ± 0.002 | 4.41 ± 0.003 | ND | ND | ND | ND | ND | ND | NS |
| ANM16 | 4.21 ± 0.004 | 6.00 ± 0.001 | 18.3 ± 0.333 | 106 ± 2.976 | 2.06 ± 0.029 | ND | ND | ND | 4.23 × 105 |
| ANM26 | 4.02 ± 0.002 | 4.91 ± 0.007 | ND | ND | ND | ND | ND | ND | NS |
| ANM39 | 4.13 ± 0.005 | 4.98 ± 0.008 | 32.0 ± 0.523 | 128 ± 5.456 | 2.28 ± 0.055 | 16.66 ± 0.511 | 314 ± 1.852 | 4.14 ± 0.018 | 5.06 × 105 |
| ANM58 | 3.56 ± 0.006 | 4.24 ± 0.002 | ND | ND | ND | ND | ND | ND | NS |
| ANM59 | 4.27 ± 0.006 | 5.26 ± 0.001 | 21.0 ± 0.333 | 105 ± 2.253 | 2.05 ± 0.036 | ND | ND | ND | 4.44 × 105 |
| ANM63 | 4.44 ± 0.003 | 6.39 ± 0.008 | 29.67 ± 0.856 | 203 ± 4.556 | 3.03 ± 0.033 | 13.33 ± 0.432 | 211 ± 1.201 | 3.11 ± 0.042 | 4.78 × 105 |
| ANM66 | 3.78 ± 0.008 | 4.57 ± 0.011 | ND | ND | ND | ND | ND | ND | NS |
| ANM69 | 4.38 ± 0.007 | 5.19 ± 0.012 | 33.00 ± 0.533 | 165 ± 8.335 | 2.65 ± 0.014 | 9.67 ± 0.333 | 147 ± 1.915 | 2.47 ± 0.072 | 4.12 × 105 |
| ANM73 | 4.29 ± 0.010 | 5.15 ± 0.008 | 20.30 ± 0.765 | 105 ± 9.882 | 2.05 ± 0.018 | 14.33 ± 0.778 | 172 ± 4.167 | 2.72 ± 0.256 | 5.17 × 105 |
| ANM75 | 3.57 ± 0.006 | 4.24 ± 0.002 | ND | ND | ND | ND | ND | ND | NS |
| ANM76 | 5.24 ± 0.003 | 7.99 ± 0.004 | 38.33 ± 0.344 | 311± 3.316 | 4.11 ± 0.005 | 8.67 ± 0.667 | 144 ± 6.233 | 2.44 ± 0.0329 | 5.45 × 105 |
| ANM77 | 3.68 ± 0.009 | 4.36 ± 0.009 | ND | ND | ND | 14.00 ± 0.856 | 193 ± 2.231 | 2.93 ± 0.015 | NS |
| ANM78 | 5.31 ± 0.002 | 8.13 ± 0.005 | ND | ND | ND | 17.33 ± 0.333 | 308 ± 7.325 | 4.08 ± 0.045 | NS |
| ANM79 | 5.33 ± 0.008 | 8.18 ± 0.001 | ND | ND | ND | 7.33 ± 0.667 | 122 ± 1.742 | 2.22 ± 0.082 | NS |
| ANM81 | 3.97 ± 0.003 | 4.49 ± 0.007 | ND | ND | ND | 12.33 ± 0.556 | 186 ± 2.445 | 2.86 ± 0.051 | NS |
| ANM82 | 5.22 ± 0.008 | 7.91 ± 0.005 | ND | ND | ND | 12.67 ± 0.856 | 126 ± 4.667 | 2.26 ± 0.027 | NS |
| ANM100 | 3.87 ± 0.009 | 4.58 ± 0.006 | ND | ND | ND | ND | ND | ND | NS |
| Strains a | Solubilize Zn | Catalase Activity | Oxidase Activity | Urease Activity | Chitinase Activity | Starch Hydrolysis | NH3 Prod. | Acid Prod. | Glucose Utilization | Sucrose Utilization | Produce CO2 | Produce H2S | Gram Staining |
|---|---|---|---|---|---|---|---|---|---|---|---|---|---|
| ANM9 | − b | + c | + | + | + | + | + | + | + | + | − | − | −ve d |
| ANM12 | − | + | − | − | − | + | − | − | + | + | − | − | −ve |
| ANM16 | − | + | − | + | − | + | + | + | + | + | − | − | −ve |
| ANM26 | − | + | + | + | − | + | + | + | + | + | − | − | −ve |
| ANM39 | − | + | − | − | + | + | + | + | + | + | − | − | −ve |
| ANM58 | − | + | + | + | − | + | + | − | + | + | − | − | −ve |
| ANM59 | − | + | + | + | − | − | + | + | + | + | − | − | −ve |
| ANM63 | − | + | − | − | + | + | + | + | − | − | − | − | −ve |
| ANM66 | − | + | + | − | − | − | − | + | + | + | − | − | −ve |
| ANM69 | − | + | − | − | + | − | + | + | + | + | − | − | −ve |
| ANM73 | − | + | − | − | + | + | + | + | + | + | − | − | −ve |
| ANM75 | − | + | + | − | − | + | + | + | + | + | − | − | −ve |
| ANM76 | − | + | − | − | + | + | + | + | + | + | − | − | −ve |
| ANM77 | − | + | − | − | + | + | + | + | − | − | − | − | −ve |
| ANM78 | − | + | − | − | + | + | + | + | + | − | − | − | −ve |
| ANM79 | − | + | − | − | + | + | + | + | + | + | − | − | −ve |
| ANM81 | − | + | − | − | + | + | + | − | − | − | − | − | −ve |
| ANM82 | − | + | − | − | + | + | + | + | − | − | − | − | −ve |
| ANM100 | − | + | − | − | − | + | − | + | + | + | − | − | −ve |
| Strains | Salinity Tolerance a | pH b | Heavy Metals c | ||||||||||
|---|---|---|---|---|---|---|---|---|---|---|---|---|---|
| 1.6 dS m−1 (Normal) | 4.0 dS m−1 | 8.0 dS m−1 | 12.0 dS m−1 | 4.0 | 5.0 | 6.8 | 9.0 | 10.0 | Hg | Zn | Cu | Cr | |
| ANM9 | 2.38 ± 0.013 d | 2.15 ± 0.007 | 1.53 ± 0.009 | 1.46 ± 0.005 | 0.20 ± 0.005 | 0.29 ± 0.007 | 0.79 ± 0.001 | 0.21 ± 0.006 | 0.17 ± 0.003 | ++ e | ++ | − g | − |
| ANM12 | 2.01 ± 0.001 | 1.56 ± 0.002 | 1.58 ± 0.005 | 1.33 ± 0.007 | 0.21 ± 0.007 | 0.31 ± 0.004 | 0.69 ± 0.005 | 0.26 ± 0.005 | 0.20 ± 0.004 | ++ | − | − | + |
| ANM16 | 1.95 ± 0.003 | 1.59 ± 0.005 | 1.84 ± 0.008 | 1.79 ± 0.010 | 0.37 ± 0.003 | 0.38 ± 0.005 | 0.78 ± 0.003 | 0.31 ± 0.008 | 0.18 ± 0.002 | ++ | + f | − | − |
| ANM26 | 1.51 ± 0.015 | 1.72 ± 0.006 | 1.69 ± 0.009 | 1.33 ± 0.005 | 0.22 ± 0.001 | 0.35 ± 0.015 | 0.66 ± 0.009 | 0.33 ± 0.009 | 0.21 ± 0.003 | + | ++ | ++ | − |
| ANM39 | 1.84 ± 0.023 | 1.16 ± 0.002 | 1.23 ± 0.011 | 1.21 ± 0.006 | 0.16 ± 0.012 | 0.29 ± 0.003 | 0.65 ± 0.005 | 0.27 ± 0.002 | 0.15 ± 0.006 | − | ++ | + | − |
| ANM58 | 1.77 ± 0.017 | 0.59 ± 0.001 | 0.89 ± 0.005 | 0.54 ± 0.008 | 0.13 ± 0.007 | 0.33 ± 0.001 | 0.73 ± 0.008 | 0.22 ± 0.007 | 0.11 ± 0.006 | − | + | − | ++ |
| ANM59 | 2.37 ± 0.011 | 2.08 ± 0.002 | 1.59 ± 0.006 | 1.48 ± 0.007 | 0.18 ± 0.005 | 0.28 ± 0.006 | 0.72 ± 0.003 | 0.27 ± 0.004 | 0.14 ± 0.004 | + | ++ | ++ | − |
| ANM63 | 2.53 ± 0.005 | 1.75 ± 0.026 | 1.79 ± 0.004 | 1.61 ± 0.013 | 0.14 ± 0.004 | 0.27 ± 0.003 | 0.64 ± 0.006 | 0.25 ± 0.011 | 0.11 ± 0.003 | ++ | − | ++ | − |
| ANM66 | 2.39 ± 0.004 | 1.43 ± 0.002 | 1.11 ± 0.005 | 1.43 ± 0.008 | 0.14 ± 0.006 | 0.21 ± 0.007 | 0.77 ± 0.013 | 0.20 ± 0.007 | 0.11 ± 0.002 | − | ++ | − | ++ |
| ANM69 | 1.67 ± 0.006 | 1.42 ± 0.003 | 1.30 ± 0.007 | 1.32 ± 0.002 | 0.19 ± 0.004 | 0.21 ± 0.004 | 0.69 ± 0.002 | 0.23 ± 0.003 | 0.18 ± 0.005 | ++ | ++ | − | − |
| ANM73 | 2.04 ± 0.002 | 1.77 ± 0.001 | 1.46 ± 0.004 | 1.16 ± 0.007 | 0.17 ± 0.003 | 0.33 ± 0.008 | 0.70 ± 0.001 | 0.30 ± 0.006 | 0.15 ± 0.002 | + | − | ++ | − |
| ANM75 | 2.13 ± 0.006 | 1.91 ± 0.004 | 1.34 ± 0.001 | 1.17 ± 0.005 | 0.17 ± 0.008 | 0.24 ± 0.003 | 0.65 ± 0.002 | 0.23 ± 0.001 | 0.16 ± 0.013 | − | ++ | + | − |
| ANM76 | 2.43 ± 0.002 | 1.92 ± 0.002 | 1.93 ± 0.007 | 1.94 ± 0.005 | 0.19 ± 0.009 | 0.35 ± 0.007 | 0.68 ± 0.004 | 0.29 ± 0.008 | 0.18 ± 0.001 | ++ | − | − | − |
| ANM77 | 1.97 ± 0.006 | 1.68 ± 0.003 | 1.37 ± 0.009 | 1.15 ± 0.006 | 0.14 ± 0.014 | 0.28 ± 0.001 | 0.71 ± 0.007 | 0.24 ± 0.006 | 0.12 ± 0.009 | ++ | + | − | − |
| ANM78 | 1.65 ± 0.020 | 1.33 ± 0.005 | 1.22 ± 0.008 | 1.11 ± 0.009 | 0.20 ± 0.001 | 0.26 ± 0.003 | 0.66 ± 0.002 | 0.23 ± 0.002 | 0.25 ± 0.001 | + | ++ | − | + |
| ANM79 | 1.83 ± 0.012 | 1.86 ± 0.009 | 1.54 ± 0.006 | 1.33 ± 0.010 | 0.10 ± 0.003 | 0.17 ± 0.010 | 0.64 ± 0.008 | 0.17 ± 0.007 | 0.11 ± 0.009 | − | − | ++ | + |
| ANM81 | 2.09 ± 0.015 | 1.53 ± 0.006 | 1.39 ± 0.004 | 1.21 ± 0.007 | 0.16 ± 0.007 | 0.20 ± 0.005 | 0.63 ± 0.011 | 0.18 ± 0.008 | 0.15 ± 0.003 | − | + | + | − |
| ANM82 | 2.15 ± 0.016 | 1.85 ± 0.011 | 1.93 ± 0.008 | 1.44 ± 0.012 | 0.14 ± 0.001 | 0.20 ± 0.007 | 0.71 ± 0.003 | 0.19 ± 0.014 | 0.13 ± 0.008 | ++ | − | ++ | − |
| ANM100 | 2.53 ± 0.002 | 2.38 ± 0.005 | 0.84 ± 0.005 | 1.90 ± 0.003 | 0.16 ± 0.005 | 0.28 ± 0.003 | 0.73 ± 0.007 | 0.24 ± 0.001 | 0.15 ± 0.006 | ++ | ++ | − | + |
| Endophytic Strains * | Shoot Length (cm) | Root Length (cm) | Shoot Fresh Biomass (g) | Root Fresh Biomass (g) | Shoot Dry Biomass (g) | Root Dry Biomass (g) | Number of Nodules | Nodules Fresh Weight (g) | Nodules Dry Weight (g) |
|---|---|---|---|---|---|---|---|---|---|
| Control | 13.83 ± 1.763 d | 15.80 ± 0.878 d | 1.11 ± 0.058 d | 0.86 ± 0.002 b | 0.27 ± 0.012 f | 0.20 ± 0.005 b | 0.00 ± 0.000 d | 0.00 ± 0.000 f | 0.00 ± 0.000 f |
| ANM16 | 23.83 ± 1.333 ab | 25.43 ± 0.240 bc | 1.39 ± 0.058 cd | 1.19 ± 0.028 ab | 0.35 ± 0.023 e | 0.25 ± 0.023 ab | 5.33 ± 0.853 abc | 0.07 ± 0.009 cd | 0.04 ± 0.008 cd |
| ANM39 | 18.27 ± 1.790 bcd | 29.60 ± 0.416 ab | 1.71 ± 0.115 abc | 1.40 ± 0.114 a | 0.43 ± 0.012 bc | 0.34 ± 0.017 a | 6.33 ± 0.667 ab | 0.12 ± 0.006 b | 0.08 ± 0.003 b |
| ANM59 | 25.50 ± 1.857 a | 21.13 ± 0.862 c | 1.59 ± 0.153 bc | 1.29 ± 0.115 ab | 0.37 ± 0.015 de | 0.29 ± 0.012 ab | 5.67 ± 0.882 abc | 0.08 ± 0.005 c | 0.05 ± 0.005 c |
| ANM63 | 21.67 ± 1.301 abc | 28.60 ± 0.954 ab | 1.55 ± 0.109 c | 1.37 ± 0.173 ab | 0.38 ± 0.029 cde | 0.31 ± 0.014 b | 4.67 ± 0.899 bc | 0.07 ± 0.003 d | 0.03 ± 0.003 de |
| ANM69 | 22.20 ± 1.595 abc | 23.13 ± 0.960 c | 1.65 ± 0.079 abc | 1.22 ± 0.058 ab | 0.41 ± 0.005 cd | 0.27 ± 0.017 ab | 3.67 ± 0.333 c | 0.05 ± 0.003 e | 0.02 ± 0.005 e |
| ANM73 | 17.50 ± 1.153 cd | 30.37 ± 0.829 a | 1.87 ± 0.051 ab | 1.47 ± 0.017 a | 0.48 ± 0.024 ab | 0.35 ± 0.029 a | 7.00 ± 0.577 ab | 0.14 ± 0.005 a | 0.09 ± 0.004 ab |
| ANM76 | 25.87 ± 1.718 a | 31.60 ± 0.896 a | 1.97 ± 0.155 a | 1.56 ± 0.141 a | 0.50 ± 0.021 a | 0.37 ± 0.108 a | 7.33 ± 0.882 a | 0.15 ± 0.005 a | 0.10 ± 0.005 a |
| LSD (p ≤ 0.05) ** | 5.763 | 4.340 | 0.3146 | 0.5097 | 0.060 | 0.130 | 2.450 | 0.020 | 0.020 |
| Endophytic Strains | Identified Species | Accession Number | Closely Related Organism | BP | Similarity |
|---|---|---|---|---|---|
| ANM59 | Paenibacillus polymyxa | KX788870 | Paenibacillus polymyxa | 719 bp | 99% |
| ANM76 | Paenibacillus sp. | KX788871 | Paenibacillus sp. | 629 bp | 86.9% |
© 2019 by the authors. Licensee MDPI, Basel, Switzerland. This article is an open access article distributed under the terms and conditions of the Creative Commons Attribution (CC BY) license (http://creativecommons.org/licenses/by/4.0/).
Share and Cite
Ahmad, M.; Naseer, I.; Hussain, A.; Zahid Mumtaz, M.; Mustafa, A.; Hilger, T.H.; Ahmad Zahir, Z.; Minggang, X. Appraising Endophyte–Plant Symbiosis for Improved Growth, Nodulation, Nitrogen Fixation and Abiotic Stress Tolerance: An Experimental Investigation with Chickpea (Cicer arietinum L.). Agronomy 2019, 9, 621. https://doi.org/10.3390/agronomy9100621
Ahmad M, Naseer I, Hussain A, Zahid Mumtaz M, Mustafa A, Hilger TH, Ahmad Zahir Z, Minggang X. Appraising Endophyte–Plant Symbiosis for Improved Growth, Nodulation, Nitrogen Fixation and Abiotic Stress Tolerance: An Experimental Investigation with Chickpea (Cicer arietinum L.). Agronomy. 2019; 9(10):621. https://doi.org/10.3390/agronomy9100621
Chicago/Turabian StyleAhmad, Maqshoof, Iqra Naseer, Azhar Hussain, Muhammad Zahid Mumtaz, Adnan Mustafa, Thomas H. Hilger, Zahir Ahmad Zahir, and Xu Minggang. 2019. "Appraising Endophyte–Plant Symbiosis for Improved Growth, Nodulation, Nitrogen Fixation and Abiotic Stress Tolerance: An Experimental Investigation with Chickpea (Cicer arietinum L.)" Agronomy 9, no. 10: 621. https://doi.org/10.3390/agronomy9100621
APA StyleAhmad, M., Naseer, I., Hussain, A., Zahid Mumtaz, M., Mustafa, A., Hilger, T. H., Ahmad Zahir, Z., & Minggang, X. (2019). Appraising Endophyte–Plant Symbiosis for Improved Growth, Nodulation, Nitrogen Fixation and Abiotic Stress Tolerance: An Experimental Investigation with Chickpea (Cicer arietinum L.). Agronomy, 9(10), 621. https://doi.org/10.3390/agronomy9100621








